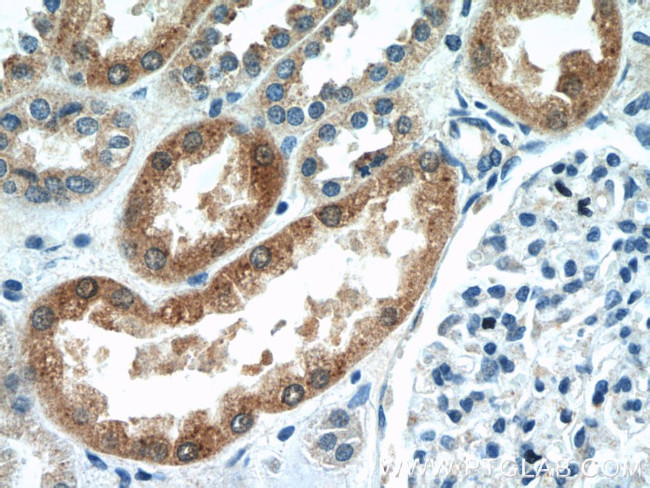
CYP4F8 Antibody in Immunohistochemistry (Paraffin) (IHC (P))
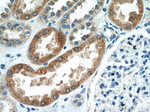
CYP4F8 Antibody in Immunohistochemistry (Paraffin) (IHC (P))

Search
Proteintech
CYP4F8 Polyclonal Antibody
{{$productOrderCtrl.translations['antibody.pdp.commerceCard.promotion.promotions']}}
{{$productOrderCtrl.translations['antibody.pdp.commerceCard.promotion.viewpromo']}}
{{$productOrderCtrl.translations['antibody.pdp.commerceCard.promotion.promocode']}}: {{promo.promoCode}} {{promo.promoTitle}} {{promo.promoDescription}}. {{$productOrderCtrl.translations['antibody.pdp.commerceCard.promotion.learnmore']}}
产品信息
20011-1-AP
种属反应
宿主/亚型
分类
类型
抗原
偶联物
形式
浓度
规格
纯化类型
保存液
内含物
保存条件
运输条件
产品详细信息
The antibody is specific to CYP4F8. The antibody has no cross reaction to other CYP4F members.
靶标信息
CYP4F8 is a member of the cytochrome P450 superfamily of enzymes. The cytochrome P450 proteins are monooxygenases which catalyze many reactions involved in drug metabolism and synthesis of cholesterol, steroids and other lipids. This protein localizes to the endoplasmic reticulum and functions as a 19-hydroxylase of prostaglandins in seminal vesicles.
仅用于科研。不用于诊断过程。未经明确授权不得转售。
篇参考文献 (0)
生物信息学
蛋白别名: CYPIVF8; Cytochrome P450 4F8; cytochrome P450, family 4, subfamily F, polypeptide 8; cytochrome P450, subfamily IVF, polypeptide 8; flavoprotein-linked monooxygenase; microsomal monooxygenase; unnamed protein product
基因别名: CPF8; CYP4F8; CYPIVF8
UniProt ID: (Human) P98187
Entrez Gene ID: (Human) 11283